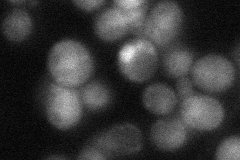
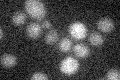

View description
Ubiquitin-protein ligase (E3) that interacts with Rpt4p and Rpt6p, two subunits of the 19S particle of the 26S proteasome; cytoplasmic E3 involved in the degradation of ubiquitin fusion proteins
Localization:
Intensity:
Fold change:
Significance:
-
C’ GFP library in SD

below threshold15.54 -
N' NOP1pr-GFP in SD

cytosol,nucleus104.586 -
N' TEF2pr-mCherry in SD

nucleus106.832 -
N' NATIVEpr-GFP in SD
nucleus33.8272 -
N' TEF2pr-VC and Cyto-VN in SD

#N/A0 -
C’ GFP library in SD+DTT

cytosol14.780.95No -
C’ GFP library in SD+H2O2

cytosol18.281.17No -
C’ GFP library in Starvation Media
cytosol15.691No -
C’ GFP library on the background of Pup2-DaMP

below threshold -
C’ GFP library on the background of CCT mutant

below threshold19.86651.27754No
